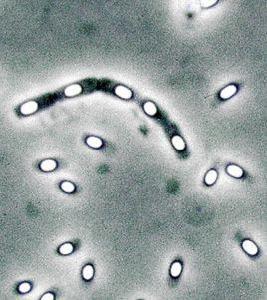
乳酸克魯維酵母 乳酸克魯維酵母

生理特徵
 乳酸克魯維酵母
乳酸克魯維酵母乳酸克魯維酵母的細胞形態一般為球形或橄攬形,與釀酒酵母的細胞形態有些相似。雖然茵株間的自然習性有一定差別,但是乳酸克魯維酵母的絕大多數菌株都分離自主要碳源為乳搪的牛奶製品中。這些菌株在以乳糖為碳源的培養基中生長良好而釀酒酵母則不能在這樣的培養基中生長,因為釀酒酵母中缺少乳糖利用的相關基因。另外與釀酒酵母比較,在釀酒酵母中發酵代謝占主導地位,而包括乳酸克魯維酵母在內的一些其他酵母種類,從本質上來說是屬於好氧微生物。
乳酸克魯維酵母在培養時,會散發山特別的類似水果的香氣,因此很容易與釀灑酵母及其他酵母如畢赤酵母的培養物區分開。水果香氣的產生說明乳酸克魯維酵母在發酵培養過程中產生了有機的酸性醋類物質。大多數的乳酸克魯維酵母菌株在嚴格的厭氧條化下培養並不能夠生長,即使在培養基中加入留醇類和脂肪酸類物質也不能改變這種情況。
在好氧條件下培養時,乳酸克魯維酵母可以發酵代謝葡萄糖從而形成乙醇,而與此同時乳酸克魯維酵母的有氧代謝呼吸系統在其生長過程中同樣行使功能,這與在釀酒醇母中發生的情況有非常人的區別。乳酸克魯維酵母中的有氧代謝呼吸系統對葡萄糖抑制現象並不敏感。實際上除了粟酒裂殖酵母之外,許多通常被認為是專性好氧菌的"陰性小幽落酵母",都不會受到葡萄糖抑制作用的影響。當釀酒酵母在葡萄糖培養基上生長時,即使在有氧培養條件下也還是以乙醇發酵代謝為主,只有當培養基中的葡萄糖含量接近耗盡時,有氧呼吸代謝途徑才被誘導激活。這與乳酸克魯維酵母在巧氧條件下對葡萄糖的利用有非常明顯的差異。
生長及生命周期
乳酸克魯維酵母能夠利用的碳源非常廣泛,纖維二糖、山梨糖、2,3-丁二醇等其他酵母不易利用的碳源在乳酸克魯維酵母中都可以得到利用。在實驗室的研究過程中,培養乳酸克魯維酵母所巧用的培養條件一般與培養釀酒酵母所使用的培養條件相似。完全培養基成分為1%的酵母提取物(W/V)、2%的蛋白腖(W/V)及實驗所需的碳源,一般為2%的葡萄糖(YPD培養基)或者2%的乳糖(YPL培養基)。乳酸克魯維醇母通常的生長溫度為25至30°C,溫度上限通常為40’℃,而經過50°C,10 min的熱衝擊處理會導致大部分的乳酸克魯維酵母死亡。作為一種子囊菌出芽酵母,乳酸克魯維酵母的生命周期與釀酒酵母非常相似,但是也略有不同。乳酸克魯維酵母通常為異宗配合,對應的兩個接合巧分別為a駛和a型。在乳酸克魯維酵母的生命周期中單倍體非常穩定而二倍體時期非常短暫且不穩定,培養中的二倍體細胞自發的形成孢子。通過在低營養含量的培養基中培養也可成功的獲得孢子四分體,進而用於後續的篩選和分析實驗。
糖類及能量代謝
乳酸克魯維酵母在有氧的巧養條件下可以在半乳糖、乳糖、庶糖和遣巧糖等糖類的培養基中生長,而在氧氣化用受限的低氧或無氧狀態下則不能生長,這就所謂的"克魯維效應"。這種現象的產生最巧的解釋是乳酸克魯維酵母在厭氧的條件下缺少運輸糖類的能力。在嚴格的慶氧條件下乳酸克魯維酵母不只是不能在葡萄糖中生長,而是不能在任何糖類中生長,即使在加入如麥角固醇和不飽和脂肪酸作為"存活因子"的培養條件下也是同樣的結果。能夠利用乳糖是乳酸克魯維酵母的重要特性。乳酸克魯維酵母對葡萄糖利用的初始磷酸化是通過RAG5基因編碼的己糖激酶實現的。
工業套用
 乳酸克魯維酵母
乳酸克魯維酵母乳酸克魯維酵母是生物技術科學領域非常重要的非釀酒酵母之一,其意義主要體現在兩個方面:在食品行業中安全套用的歷史和工業規模化生產酶的能力。1993年,第一次有文獻綜述了其作為異源蛋白表達系統的套用,文中提及了已有8種蛋白在這一系統中成功獲取表達。到今天,這一數量己增長到40多種。
乳酸克魯維酵母作為蛋白表達系統在食品行業的成功套用,意味著其也可以套用於醫藥行業進行大規模的藥用蛋白的生產。事實上,許多藥用相關蛋白已在乳酸克魯維酵母中成功表達,比如哺乳動物蛋白白介素1-P、干擾素α、β-乳球蛋白、溶菌酶和胰島素前體等。在醫藥領域的套用,乳酸克魯維酵母(和其他酵母、真菌表達系統一樣)的一個缺點就是對分泌的蛋白都會進行一定的糖基化修飾,並且這種修飾與人體內糖基化模式是不同的,這會對藥用蛋白的半衰期、組織分布和免疫原性產生不利的影響。當然,通過改變酵母體內糖基化的方式,使其生產的蛋白能夠滿足人體內的糖基化模式,是可以使藥用蛋白發揮效果的,這一有前景的技術對於乳酸克魯維酵母也是適用的。